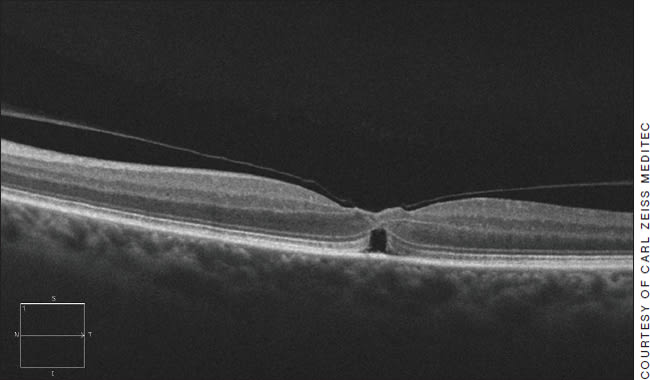

General Ophthalmologists & Retinal Issues
OCT provides new opportunities but it has limitations.
By Steven M. Silverstein, MD, FACS
Like most anterior segment comprehensive ophthalmologists, I have been gratified that the availability of optical coherence tomography over the past decade has added a valuable new dimension to my practice, and provided me with numerous opportunities to help patients in a more timely and effective manner.
Prior to the availability of OCT, I could usually detect macular pathology, but understanding the extent of the disease required fluorescein angiography, referral to a retinal specialist, or both. Currently, by employing OCT, I am able to accurately diagnose and, in specific instances, appropriately treat some of these cases without the need for FA or referral. However, I also recognize that I must use the capabilities of OCT in a cautious and judicious manner.
The arrival of OCT in our practices is a milestone development that gives us a wider, but limited, latitude in dealing with retinal issues. In this article, I will examine how anterior segment specialists can now do more for patients with very specific retinal problems.
With OCT, we can also provide valuable information to our retinal colleagues so that our referrals can be timely and well-documented rather than vague and at times unsubstantiated. The end result can be much improved communication between general ophthalmologists and retina specialists, leading to a more productive “team approach” in dealing with our patients' retinal issues.
What We Can Handle: CME After Cataract Surgery
Cystoid macular edema following cataract surgery is the most common complication, typically appearing four to six weeks postoperatively. According to the literature, CME following cataract surgery presents in an estimated 5% to 15% of cases. Prior to the availability of OCT, many of these cases were referred to retina specialists. Anterior segment ophthalmologists who now have experience with OCT have become comfortable in diagnosing and treating CME following cataract surgery. We have also learned more about preventing this complication.

How Dr. Silvertsein tackles postoperative CME. The figure on the left is an OCT image of CME that presented following cataract surgery. The figure on the right is an OCT image showing the CME resolved following treatment. Dr. Silverstein combats postop CME with a treatment regimen consisting of NSAIDs and the anti-inflammatory steroidal Durezol. He also uses these medications preoperatively as prophylaxis to prevent CME.
My confidence in diagnosing, treating and preventing postoperative CME has grown in recent years thanks to OCT and also to some newer and highly effective medications that can be used as both preoperative prophylaxis to prevent CME and as potent treatments to combat it (see accompanying images). My choices in this regard are a combination of one of the leading NSAIDs and Alcon's new “supersteroid” topical Durezol. I have found this combination highly useful as a major weapon in my anti-CME arsenal. In addition, sub-Tenon's or intravitreal steroid injections can be effective in treating CME.
OCT evaluation can reveal macular holes (such as the one pictured) that are best referred to a retina specialist, and pseudomacular holes, which can generally be observed.
OCT Cannot Replace FA
Retina specialists regularly use FA to diagnose and treat such problems as tumors, diabetic retinopathy and retinal vein occlusions. There can be a temptation among some anterior segment ophthalmologists to substitute OCT for FA. This may lead to occasional misdiagnosis.
As highly respected retinal specialist Carl Awh, MD, of Nashville, Tenn., cautions: “I encourage the use of OCT by general ophthalmologists. Improved diagnosis leads to more timely and appropriate referrals. It is, however, important to not place too much reliance upon OCT as a diagnostic tool. Thankfully, these devices aren't able to replace us — yet!
“With OCT, a device that can be operated by any competent ophthalmic technician can quickly demonstrate subtle variations in macular anatomy that were formerly revealed only by skilled clinical examination,” he continues. “However, keep in mind that structural abnormalities, such as macular edema, can be related to functional abnormalities that are not apparent on OCT.
Dr. Awh notes that choroidal neovascularization, diabetic retinopathy and venous occlusive disease can cause cystoid macular edema but can easily be missed by OCT.
“Clinical correlation is critical, and fluorescein and ICG angiography are still necessary for a thorough understanding of the mechanism of many macular problems,” he asserts.
And heed this cautionary note from another respected retina specialist, Jordan Graff, MD, of Barnet Dulaney Perkins Eye Centers in Phoenix.
“Don't overestimate the interpretive powers of OCT,” he advises. “FA, ICG angiography, peripheral exam and ultrasound can provide additional important information that is needed to diagnose and manage a problem. For example, I was referred a case where the source of edema was thought to be macular degeneration based on pre-existing drusen and OCT imaging alone. When we did additional examination and testing, we found that the cause of the edema was an amelanotic melanoma. Pre-referral counseling based on OCT imaging alone can make for a surprised and confused patient when the full clinical picture is presented.”
Premium IOLs and OCT
I have read recent articles written by cataract surgeons who use OCT imaging for every premium IOL candidate to determine if patients may have retinal issues that would affect their suitability for certain types of premium lenses. In my experience, I can usually make an accurate judgment concerning a patient's IOL suitability by performing a thorough examination using an indirect ophthalmoscope and a 60-diopter lens and biomicroscopy. Sometimes, however, it is necessary to employ OCT to evaluate subtle macular pathology that may suggest that a patient is not an ideal premium IOL candidate.
OCT has quickly become one of the two most-billed for diagnostic procedures and, as a result, has been red-flagged by insurers. This potentially drives down the reimbursement for this important test and, therefore, should be billed for on a case-by-case basis, if a physician prefers to obtain an OCT for all premium channel patients.
Other Ways OCT Can be Helpful
It's very rewarding when I can use OCT technology to differentiate between a macular hole and a pseudomacular hole. A fresh macular hole triggers referral to a retina specialist. The pseudomacular hole is a problem that may be carefully observed if the vision and vitreo-macular interface is stable. Additionally, when I diagnose wet AMD, the patient is referred to a retinal specialist for early intervention.
I prefer to refer patients for anti-VEGF injections to retina specialists because in our large city we have a number of experienced, well-qualified doctors who perform these injections many times each day.
However, if I practiced in a rural area where patients had to travel a great distance to receive medical care, I would perform the injections myself.
Fostering a Team Approach
I believe that having OCT and being able to make accurate diagnoses is creating better relationships between anterior segment surgeons and retinal specialists.
Dr. Graff agrees. “Overall, it is a positive development for anterior segment ophthalmologists to have OCT,” he asserts. “It leads to insightful consultations and more guided requests for retina evaluation. Just being able to clearly identify the presence of edema is very valuable.”
But Dr. Graff's enthusiasm is tempered by some concerns. “Anterior segment ophthalmologists have to use a great deal of caution in attempting to manage a retinal issue,” he says. “Using OCT alone to attempt to manage a serious retinal problem is really overreaching.”
It is incumbent on anterior segment ophthalmologists to use OCT imaging judiciously and appropriately, recognizing that it is only one diagnostic tool in a much larger arsenal of tools. By providing more — and more accurate — information to our retina colleagues, we can move toward a more team-based approach to retinal issues that will benefit us, our retina colleagues and, most of all, our patients. OM

| Steven M. Silverstein, MD, FACS, is a regular contributor to Ophthalmology Management and often lectures on ophthalmic topics. He is the owner of Silverstein Eye Centers, based in Kansas City, Mo. In addition to his private practice, Dr. Silverstein serves as an assistant professor of Ophthalmology at the University of Missouri Kansas City Medical School, and clinical professor of Ophthalmology at Kansas City University of Medicine and Biosciences. Dr. Silverstein can be reached via e-mail at ssilverstein@silversteineyecenters.com. |








